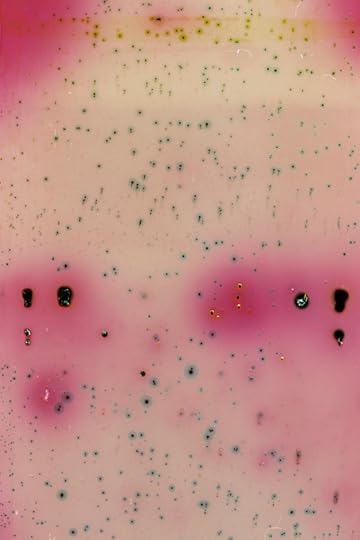

Emily M. Danforth's Blog, page 17
April 9, 2014
"So many of the writers I love seem to be fed by many diverse streams. They are like mash-up artists,..."
- Karen Russell (via mttbll)
April 8, 2014
publishersweekly:
Madame Bovary in Pie Chart Form.
April 7, 2014
fer1972:
Water Paintings: Sarah Harvey
April 5, 2014
keprojects:
See it today! Sebastian Masuda | Colorful Rebellion...

Sebastian Masuda, Colorful Rebellion - Seventh Nightmare exhibition at Kianga Ellis Projects Feb 28 - March 29, 2014. Photo by GION

Sebastian Masuda, Colorful Rebellion - Seventh Nightmare exhibition at Kianga Ellis Projects Feb 28 - March 29, 2014. Photo by GION

Sebastian Masuda, Colorful Rebellion - Seventh Nightmare exhibition at Kianga Ellis Projects Feb 28 - March 29, 2014. Photo by GION

Sebastian Masuda, Colorful Rebellion - Seventh Nightmare exhibition at Kianga Ellis Projects Feb 28 - March 29, 2014. Photo by GION

Sebastian Masuda, Colorful Rebellion - Seventh Nightmare exhibition at Kianga Ellis Projects Feb 28 - March 29, 2014. Photo by GION

Sebastian Masuda, Colorful Rebellion - Seventh Nightmare exhibition at Kianga Ellis Projects Feb 28 - March 29, 2014. Photo by GION
See it today! Sebastian Masuda | Colorful Rebellion - Seventh Nightmare at Kianga Ellis Projects, 516 W. 25th Street, Studio 306B NYC. Gallery hours: Wed - Sat, 11am - 6pm. Photos by GION.
artchipel:
INVITATION
Chloe Early (b.1980, Ireland)
Working in...





Chloe Early (b.1980, Ireland)
Working in oils on linen and aluminium panel, Cork-born artist Chloe Early has developed a unique style that is simultaneously lush and raw. The romantic and the gritty meet in her paintings, which tease out a distinctively poetic worldview through the juxtaposition of extremes. At their core is a sensitivity to lyrical feelings and themes - love, beauty, innocence and softness - which collide with more worldly symbols of aggression and degradation, such as bullets, bombs, urban refuse and ruins. Graduated from NCAD in Dublin in 2003, Chloe moved to London in 2004 where she has lived and worked since. Her paintings have been exhibited worldwide with group and solo shows.
Solo show Suspended @ The Outsiders London
04.04-03.05.2014
© All images courtesy the artist
[more Chloe Early | artist found at Juxtapoz]
April 3, 2014
simonschusterca:
We’re absolutely in LOVE with these new...







We’re absolutely in LOVE with these new contemporary covers for seven of our favourite Judy Blume novels, all designed and illustrated by the incredible inkygirl. What do you think?
Read about the inspiration behind the new look!
likeafieldmouse:
Nico Krijno
"If you are going to be on the artist’s side of the fence, your job is to place a bit token in the..."
- Tana French, interviewed by Amy Benfer in 2012. “Ghost Estates: Ireland After the Bubble.” (via ryansara)
likeafieldmouse:
Judit Reigl - Outburst (1958-9)
missbelivet:
Gorgeous shots of Cate Blanchett (Carol) &...


Gorgeous shots of Cate Blanchett (Carol) & Rooney Mara (Therese) by photographer Brian Douglas.
April 2, 2014 - Cincinnati